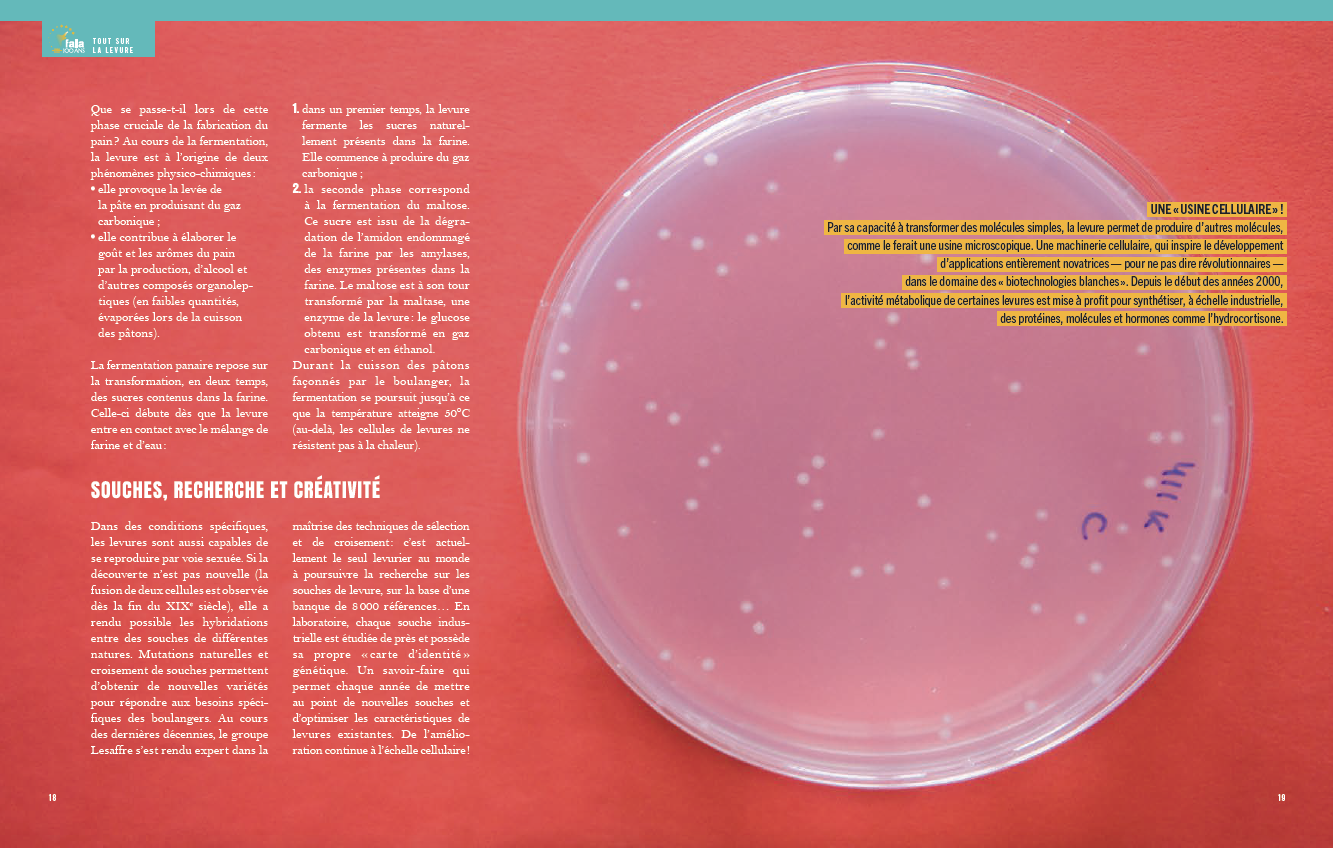

QUI SOMMES-NOUS ?
![]() est une agence de communication B to B spécialisée en rédaction et édtion :
est une agence de communication B to B spécialisée en rédaction et édtion :
- journal B to B
- livre d’entreprise
- création de contenus, multilingue & plurimédia
- site éditorial externe & interne
- magazine externe, interne, print & web
Rédaction

Durant 30 ans, chez divers agences et annonceurs, il crée de multiples supports éditoriaux (newsletters, magazines, sites internet…). Il écrit des ouvrages pour le Département de la Drôme, la FNAC, la Région Haute-Normandie et Virgin France. Il crée le magazine trimestriel « EDF Collectivités » et, pour Lesaffre, le journal B to B « L’Envol ». Au sein de Planète Tatou qu’il crée fin 2018, il rédige et supervise la réalisation de deux ouvrages : « 100 ans de passion » (180 pages) pour la Fabrique Alsacienne de Levure & Alcools, et « Quelle histoire ! » (160 pages) pour Biospringer.
Création

Fan de musique, de photo et de New-York, Jon maîtrise la création publicitaire, la création de sites web, l’édition et même le montage vidéo.

Directeur artistique polyvalent, il travaille pour l’édition, le web, des labels de musique, la télévision (« Karambolage » sur Arte).
références
Création de supports
Contenus exploités sur le site internet et les réseaux sociaux